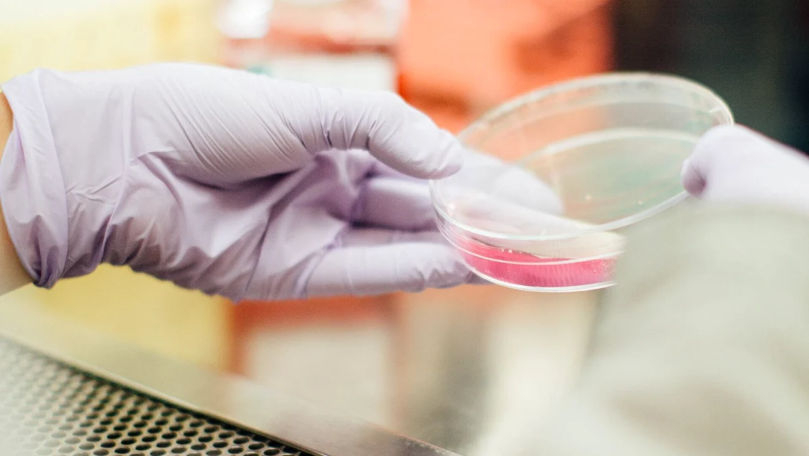
mamaplus
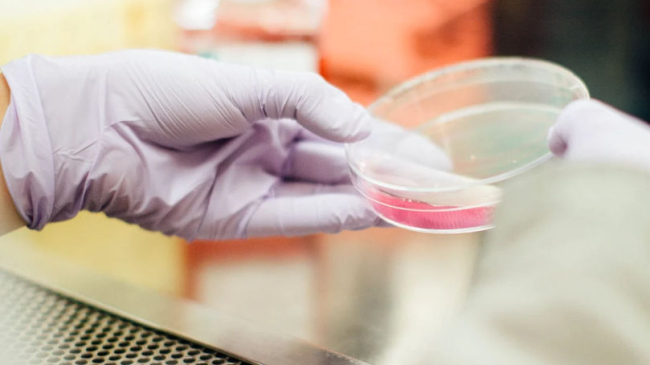
mamaplus

Oamenii de ştiinţă care urmăresc răspândirea gripei aviare sunt din ce în ce mai îngrijoraţi de faptul că lacunele în monitorizare îi pot ţine cu câţiva paşi în urma momentului izbucnirii unei noi pandemii, potrivit interviurilor Reuters cu mai mult de o duzină de experţi importanţi.
Mulţi dintre aceştia monitorizează noul subtip de gripă aviară H5N1 la păsările migratoare din 2020. Dar răspândirea virusului la 129 de turme de vaci de lapte din 12 state americane semnalează o schimbare care ar putea face aduce virusul mai aproape de a deveni transmisibil între oameni. Infecţii au fost depistate şi la alte mamifere, de la alpaca la pisici de casă, transmite adevarul.ro.
„Pare aproape ca o pandemie care se desfăşoară cu încetinitorul", a declarat Scott Hensley, profesor de microbiologie la Universitatea din Pennsylvania. "În acest moment, ameninţarea este destul de scăzută. dar asta s-ar putea schimba într-o clipă", avertizează el.
Cu cât avertizarea cu privire la un salt la om este mai timpurie, cu atât mai repede oficialii din domeniul sănătăţii mondiale pot lua măsuri pentru a proteja oamenii prin lansarea dezvoltării de vaccinuri, teste pe scară largă şi măsuri de izolare.
Monitorizarea federală a vacilor de lapte din SUA se limitează în prezent la testarea turmelor înainte ca acestea să fie transportate dintr-un stat în altul. Eforturile de testare ale statelor sunt inconsecvente, în timp ce testarea persoanelor expuse la bovinele bolnave este insuficientă, au declarat pentru Reuters oficiali guvernamentali din domeniul sănătăţii şi experţi în gripă pandemică.
„Trebuie să ştim care sunt fermele pozitive, câte dintre vaci sunt pozitive, cât de bine se răspândeşte virusul, cât timp rămân infectate aceste vaci, calea exactă de transmitere", subliniază virusologul olandez Ron Fouchier de la Centrul Medical Erasmus din Rotterdam.